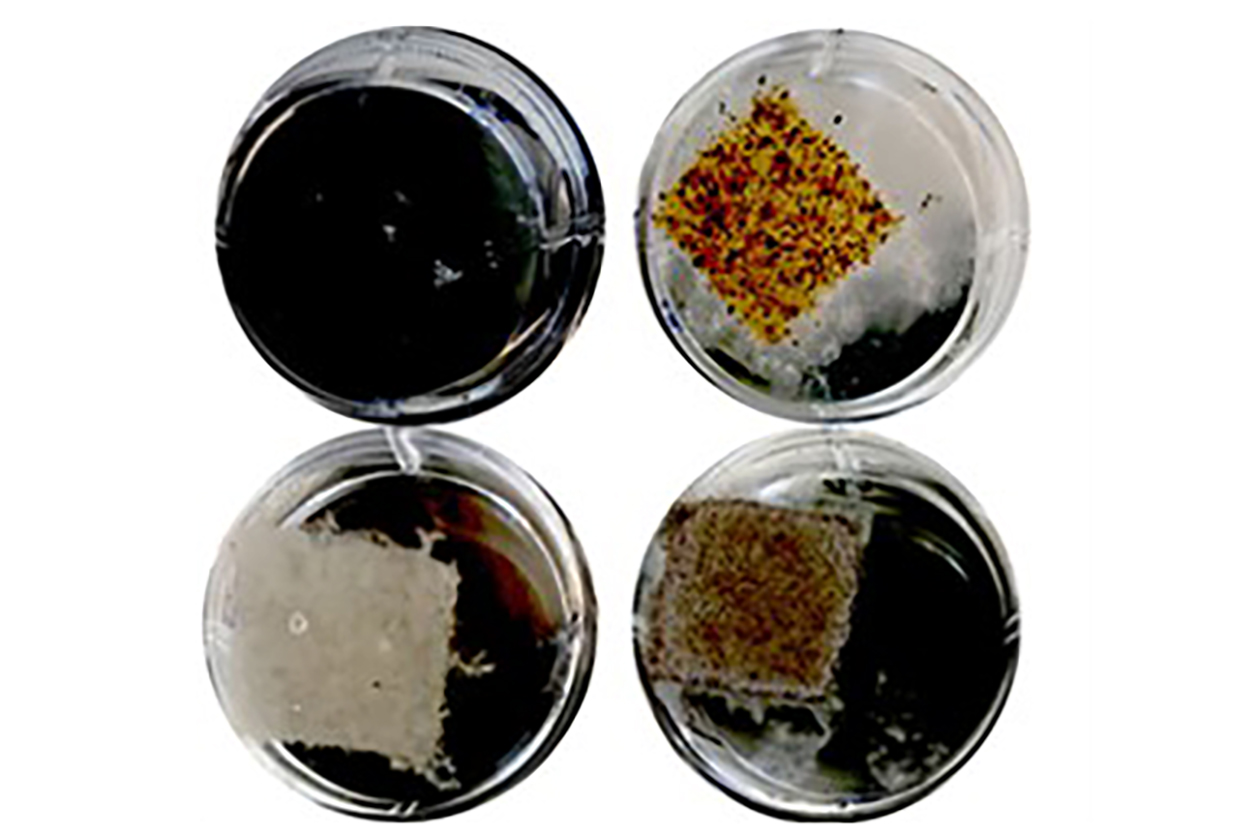

A novel technology that can efficiently bind to and break down per- and polyfluoroalkyl substances (PFAS) in the environment was developed by scientists at Texas A&M Agrilife Research(https://tools.niehs.nih.gov/srp/programs/Program_detail.cfm?Project_ID=R01ES032708) with support from an NIEHS Superfund Research Program individual research grant.
The new approach uses a plant-based material that adsorbs PFAS, and microbial fungi that literally eat up the so-called “forever chemicals.” The findings, which were published July 28 in Nature Communications, could provide a powerful solution for finally getting rid of these contaminants.
Remediation problems

PFAS, known as forever chemicals because they are so difficult to degrade, have been linked to adverse health effects in humans and wildlife. To date, methods to remediate PFAS have involved extreme heat, sorbents, and bioremediation (the use of microorganisms to break down contaminants), all of which can be costly and inefficient, and create secondary pollutants.
“PFAS are so stable because they are composed of a chain of carbon and fluorine atoms linked together, and the carbon-fluorine bond is one of the strongest chemical bonds,” said lead researcher Susie Dai, PhD., in a press release.
A certain kind of fungus known as “white rot” has shown promise to degrade PFAS, but sustaining its growth and promoting PFAS breakdown has been challenging.
To address these shortcomings, the researchers used an abundant and renewable component of dry plant matter called lignocellulose — to create a porous framework as a low-cost, efficient, and sustainable alternative for PFAS remediation. The framework, named Renewable Artificial Plant for In-Situ Microbial Environmental Remediation (RAPIMER), is made from the leaves, stalks, and cobs of corn plants left in the field after harvest.

A multi-step approach
The approach works in three steps:
- First, the lignocellulose is chemically modified to enhance the adsorption of PFAS and is incorporated into the RAPIMER framework. Adsorption occurs when molecules, ions, or atoms stick to a surface.
- Second, RAPIMER adsorbs and holds the PFAS for bioremediation while also providing nutrients for the fungi to grow.
- Third, the fungus degrades PFAS and RAPIMER itself.
“The plant’s cell wall-based material serves as a framework to adsorb the PFAS,” said Dai. “Then this material and the adsorbed chemical serve as food for a microbial fungus. The fungus eats them at the same time to eliminate the disposal problem. Basically, the fungus is doing the detoxification process.”
In the new study, the researchers found that their platform successfully bound PFAS at higher concentrations than other currently available sorbents. After two weeks, more than 98% and 99% of PFOA and PFOS, respectively, were removed. According to the team, the findings suggest that the PFAS were being degraded biologically into less toxic products.
Environmental benefits
The authors also reported that RAPIMER greatly lowers environmental impacts, including air pollution emissions and human toxicity, compared to other commercial sorbent PFAS remediation techniques.
A unique characteristic of this platform is that the PFAS binding, fungal growth, and bioremediation, which would typically occur separately, instead happen synergistically within a single material. Also, that material is derived from a renewable, abundant plant source and creates no secondary pollutants.
Overall, the RAPIMER platform combines sorbent and bioremediation techniques to achieve environmentally friendly and efficient PFAS remediation. The platform also removes co-contaminants from water, like heavy metals and other organic pollutants, which may be useful under several real-world conditions, the authors noted.
Citation: Li J, Li X, Da Y, Yu J, Long B, Zhang P, Bakker C, McCarl BA, Yuan JS, Dai SY. 2022. Sustainable environmental remediation via biomimetic multifunctional lignocellulosic nano-framework. Nat Commun 13(1):4368.
(Megan Boland is a research analyst for MDB Inc., a contractor for the NIEHS Superfund Research Program.)